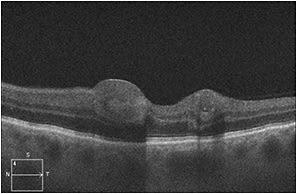
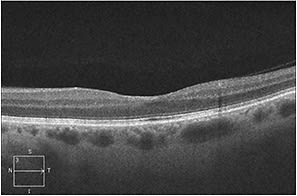

CASE STUDY
Decreased Vision Following Shunt Surgery
A glaucoma patient presents with postsurgical decompression retinopathy.
HEMANG K. PANDYA, MD • ASHEESH TEWARI, MD
A 53-year-old white woman experienced sudden-onset decreased vision in the left eye one day following glaucoma filtering surgery. Her past ophthalmic history was significant for uncomplicated cataract extraction at an outside facility earlier in the year.
Approximately one month after cataract surgery she developed IOP spikes that could not be controlled medically. She subsequently underwent glaucoma surgery with placement of an Ex-PRESS Shunt (Alcon, Fort Worth, TX) in her left eye. Her visual symptoms prompted her to seek care from a vitreoretinal specialist.
EXAMINATION AND DIAGNOSIS
On examination, the patient’s vision was 20/20 in the right eye and 20/400 in the left. Pupils were normal, without a relative afferent pupillary defect. Goldmann tonometry detected IOP of 12 and 8 mm Hg, in the right and left eyes, respectively. Confrontation fields were full to confrontation in both eyes.
Anterior-segment examination revealed an Ex-PRESS Shunt in the left eye with a patent lumen, a well-formed anterior chamber, and a centered posterior-chamber IOL within the capsular bag. Anterior segment in the right eye revealed trace nuclear sclerosis.
Examination of the right fundus was unremarkable, but the left eye revealed multiple intraretinal white-centered hemorrhages throughout the macula and periphery (Figure 1). We detected no vitritis, retinitis, or vasculitis in either eye.

Figure 1. At presentation, fundus photograph of the left eye with multiple intraretinal white-centered hemorrhages.
Hemang K. Pandya, MD, is a senior resident at the Kresge Eye Institute in Detroit. Asheesh Tewari, MD, is a vitreoretinal surgeon and fellowship director at Kresge Eye Institute and an assistant professor in the Department of Ophthalmology at Wayne State University. Neither author reports any financial interests in any product mentioned in this article. Dr. Pandya’s e-mail address is drhemangpandya@gmail.com.
Fluorescein angiography demonstrated numerous punctate areas of hypofluorescence, consistent with blockage from the intraretinal hemorrhages (Figure 2). Spectral-domain OCT scans of the macula showed lesions within the inner retina corresponding to intraretinal hemorrhages but an otherwise unremarkable outer retina with an intact inner segment/outer segment junction and retinal pigment epithelium layer (Figure 3).

Figure 2. At presentation, fluorescein angiography of the left eye in both early (A) and late phases (B) showed good perfusion and hypofluorescence, corresponding to blockage from the intraretinal hemorrhage.
Figure 3. At presentation, SD-OCT of the left eye showed lesions corresponding to the intraretinal hemorrhage with shadowing but an otherwise intact outer retina and RPE.
Differential diagnosis included retinal vein occlusion, ocular ischemic syndrome (OIS), Valsalva retinopathy, and decompression retinopathy. We diagnosed this patient with decompression retinopathy.
DISCUSSION
Alcon developed the Ex-PRESS Shunt for implantation under a partial-thickness scleral flap to control IOP in patients with primary open-angle glaucoma. This stainless steel 3-mm-long device is biocompatible, nonvalved, and MRI-compatible, and it has a 50-µm lumen that faces the anterior chamber.
Many glaucoma specialists prefer the Ex-PRESS Shunt to trabeculectomy for the low rate of hypotony of the former with comparable efficacy at controlling IOP,1 better IOP control without medication use at three years postoperatively,2 and as an alternative surgical approach following unsuccessful trabeculectomy.
Effectively, the Ex-PRESS Shunt is on the forefront of small-incision glaucoma filtering surgery and is within the glaucoma specialist’s arsenal of treatment options for controlling IOP.
Decompression retinopathy tends to occur in eyes that have very high IOP preoperatively and are rapidly decompressed intraoperatively.
Originally described following trabeculectomy, it has now been reported in various penetrating3 and nonpenetrating4 glaucoma procedures.
Fechtner et al described decompression retinopathy with a constellation of findings, including preretinal and intraretinal hemorrhages.5 Spontaneous resolution without any vision loss occurs in the majority of cases; however, in cases of macular involvement, residual scotoma or preretinal fibrosis can occur, causing permanent visual symptoms.6 Decompression retinopathy does not commonly occur following Ex-PRESS shunt implantation.7
We performed the appropriate baseline tests, including FA and SD-OCT, to rule out any other vision-threatening conditions. As demonstrated in the images, our patient’s retinal hemorrhages improved with observation (Figure 4, page 71). At three months, the patient’s best-corrected visual acuity was 20/25 with almost complete resolution of hemorrhage on fundus examination (Figure 5) and SD-OCT (Figure 6).

Figure 4. At two weeks, fundus photograph of the left eye showed partial resolution of the intraretinal hemorrhages.

Figure 5. At three months, fundus photograph of the left eye showed almost complete resolution of the intraretinal hemorrhages.
Figure 6. At three months, SD-OCT of the left eye showed complete resolution of the subfoveal intraretinal hemorrhage.
SUMMARY
Vision loss following incisional glaucoma surgery can be multifactorial, including choroidal hemorrhage, refractive error from changes in IOL positioning, and decompression retinopathy.
Observation is the mainstay of treatment for decompression retinopathy. However, baseline FA and OCT can be useful in evaluating patients for other potentially treatable causes of decreased vision. RP
REFERENCES
1. Maris PJ Jr, Ishida K, Netland PA. Comparison of trabeculectomy with ExPRESS miniature glaucoma device implanted under scleral flap. J Glaucoma. 2007;16:1:14-19.
2. de Jong L, Lafuma A, Aguade AS, Berdeaux G. Five-year extension of a clinical trial comparing the EX-PRESS glaucoma filtration device and trabeculectomy in primary open-angle glaucoma. Clin Ophthalmol. 2011;5:527-533.
3. Bansal A, Ramanathan US. Ocular decompression retinopathy after trabeculectomy with mitomycin-C for angle recession glaucoma. Ind J Ophthalmol. 2009;57:153-154.
4. Lai JSM, Lee VYW, Leung DYL, Chung TCF. Decompression retinopathy following laser peripheral iridoplasty for acute primary angle-closure. Eye. 2005;19:1345-1347.
5. Fechtner RD, Minckler D, Weinreb RN, Frangei G, Jampol LM. Complications of glaucoma surgery: ocular decompression retinopathy. Arch Ophthamol. 1992;110:965-968.
6. Feldman RM, Bell NP, eds. Complications of Glaucoma Surgery. New York, NY; Oxford University Press; 2013.
7. Samra AK, Fernando SS, Sarup V. Decompression retinopathy after ExPRESS shunt implantation for steroid-induced ocular hypertension: a case report. Case Rep Ophthalmol Med. 2011;2011:303287.








